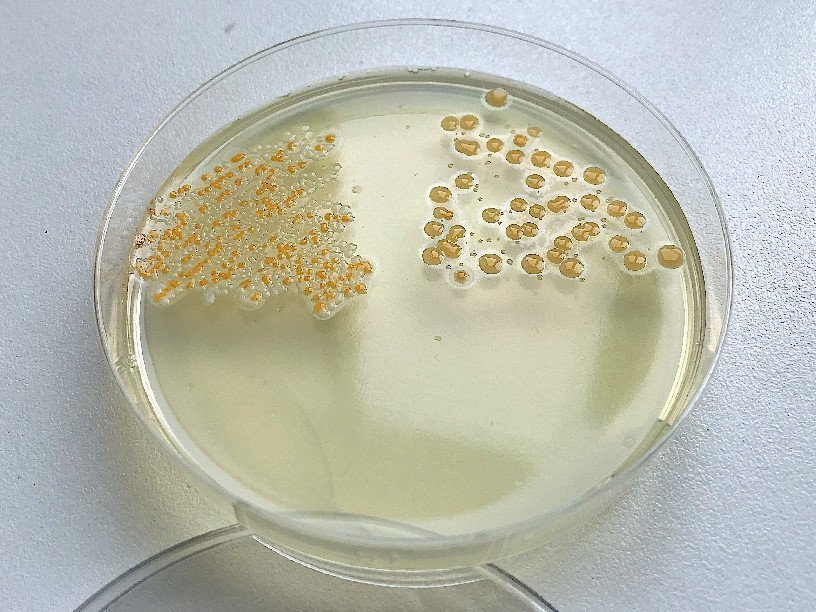

Екатерина Беленко: Промикробы: Потянуло на солененькое
А вот вы знаете происхождение слова «стафилококк»? От греческого «гроздь винограда», прелестно, да? Это название они заслужили тем, что клетки, делясь в нескольких плоскостях, укладываются в мазке ну чисто как виноградинки. Корень «кокк» — дословно «зерно, ягода» — должен сразу дать вам понять, что эти бактерии кругленькие, в отличие от палочковидных бацилл или закрученных спирохет.
⠀
Вспоминаем материал прошлых заметок и пройдёмся по характеристикам колоний. Формы колоний стафилококков на плотных питательных средах — округлые, выпуклые, пигментированные (белые, желтые, золотистые). На жидких дают равномерное помутнение. Стафилококки широко распространены в почве и вообще в воздухе, это представители нормальной кожной микрофлоры человека и животных. В состав этого рода входят патогенные и условно патогенные для человека виды, колонизирующие носоглотку, ротоглотку и кожные покровы.
⠀
В роду Staphylococcus выделяют около 30 видов, при этом 14 обнаружены на коже и слизистой человека. Самый известный и он же самый пугающий представитель рода — золотистый стафилококк. Имя получил не просто так: он реально умеет вырабатывать золотистый пигмент. Отличительной биохимической особенностью золотистого стафилококка является выработка коагулазы — фермента, свёртывающего плазму крови. То есть в крови запускается особый каскад реакций, приводящих к образованию сгустка. Не очень приятная особенность, короче. Стафилококковая коагулаза наиболее хорошо сочетается с человеческой плазмой и плазмой кроликов. Чем-то мы и кролики не угодили этим малышам.
⠀
Ещё одна отличительная особенность стафилококков — любовь ко всему солёненькому. Поэтому специально для них мы готовим питательную среду с дополнительными порциями соли. На такой среде не растут другие микроорганизмы, а стафилококку нравится. Называется эта среда «желточно-солевой агар» (ЖСА). С частью про соль мы разобрались, теперь давайте поясню, почему он желточный. Всё банально — из-за желтка в составе. Конечно, индустрия производства питательных сред для микробиологии шагнула далеко вперёд, и есть специальные среды для стафилококков, в которые дополнительно не надо добавлять пищевые продукты. Но старый добрый метод ничем не хуже.
⠀
На ЖСА вокруг колоний стафилококков, обладающих лецитиназной активностью, образуются зоны помутнения с перламутровым оттенком. Эти зоны видны (я надеюсь) на фото. Добавив желток в агар, мы внесли в него лецитины — жироподобные вещества, являющиеся смесью фосфолипидов. Если же у микробика есть инструмент для разрушения этих больших молекул, то вокруг колоний мы увидим эту самую опалесценцию.
⠀
Я тоже в каком-то смысле стафилококк, ведь подсоленная яичница — мой идеальный завтрак.